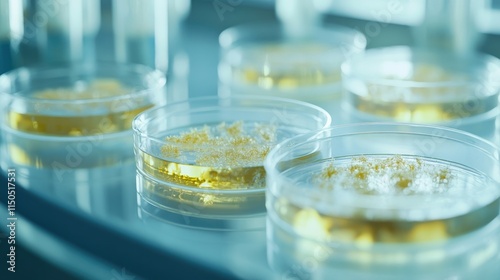

Download sample
File Details
Published: 2024-12-22 18:59:34.874749 Category: Science Type: Illustration Model release: NoShare
High-detail view of petri dishes with bacterial and fungal cultures in a controlled lab setting for scientific study.
Contributor: Pannin
ID : 1150517531

